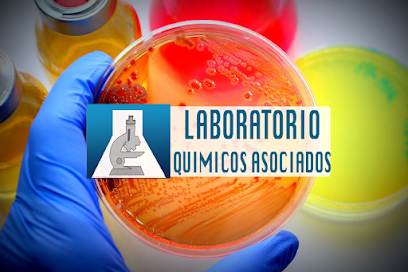
Dirección, horario, teléfono y opiniones de Análisis Clínicos Tapachula Quimicos Asociados en Tapachula

Valoración: 5 ⭐ de 1 Opiniones
El laboratorio clínico de Tapachula Chiapas, México, se encuentra ubicado en Los Naranjos, Centro, 30700 Tapachula de Córdova y Ordóñez, Chis., México, en la ciudad de Tapachula. Aunque no se dispone de información detallada sobre su horario de atención ni número de contacto, su clasificación de 5 sobre 5 basada en la opinión de 1 usuario refleja una experiencia positiva general.
Este centro médico ha sido descrito como una opción acogedora y eficiente en una ciudad que recibe a muchos migrantes, transmitiendo confianza a sus usuarios. La atención, la entrega de resultados y la variedad de pruebas disponibles son aspectos que resaltan en las valoraciones neutras o positivas recibidas.
La comunidad destaca la importancia de contar con un laboratorio de calidad en la zona, y la ubicación estratégica en la ciudad fronteriza de Tapachula lo convierte en una entrada vital para muchos migrantes. Estos comentarios subrayan la relevancia del laboratorio clínico en la comunidad local y su papel en la salud pública.
Si deseas obtener más información sobre los servicios ofrecidos por este laboratorio en Tapachula, te invitamos a contactar directamente para consultar sobre horarios, pruebas disponibles y cualquier otra información relevante para tu atención médica.
Dirección, horario y número de teléfono de Tapachula Chiapas México en Tapachula
En este apartado tienes un pequeño resumen con la información que puedes necesitar sobre Tapachula Chiapas México.
Lee las reviews de otras personas sobre este laboratorio clínico
¿Deseas que corrijamos algún dato erróneo?
Si te has percatado de algún dato equivocado en la ficha, deseas mandarnos una sugerencia o eres el dueño de este laboratorio médico, puedes contactarnos a través del formulario que tienes a tu disposición pulsando el siguiente enlace.
Encuentra otro laboratorio de análisis clínicos parecido a Tapachula Chiapas México en Tapachula
Asimismo, si no pueden hacer la prueban en Tapachula Chiapas México, desde aquí puedes acceder a las localizaciones y los teléfonos de algún otro laboratorio de análisis clínicos en Tapachula.